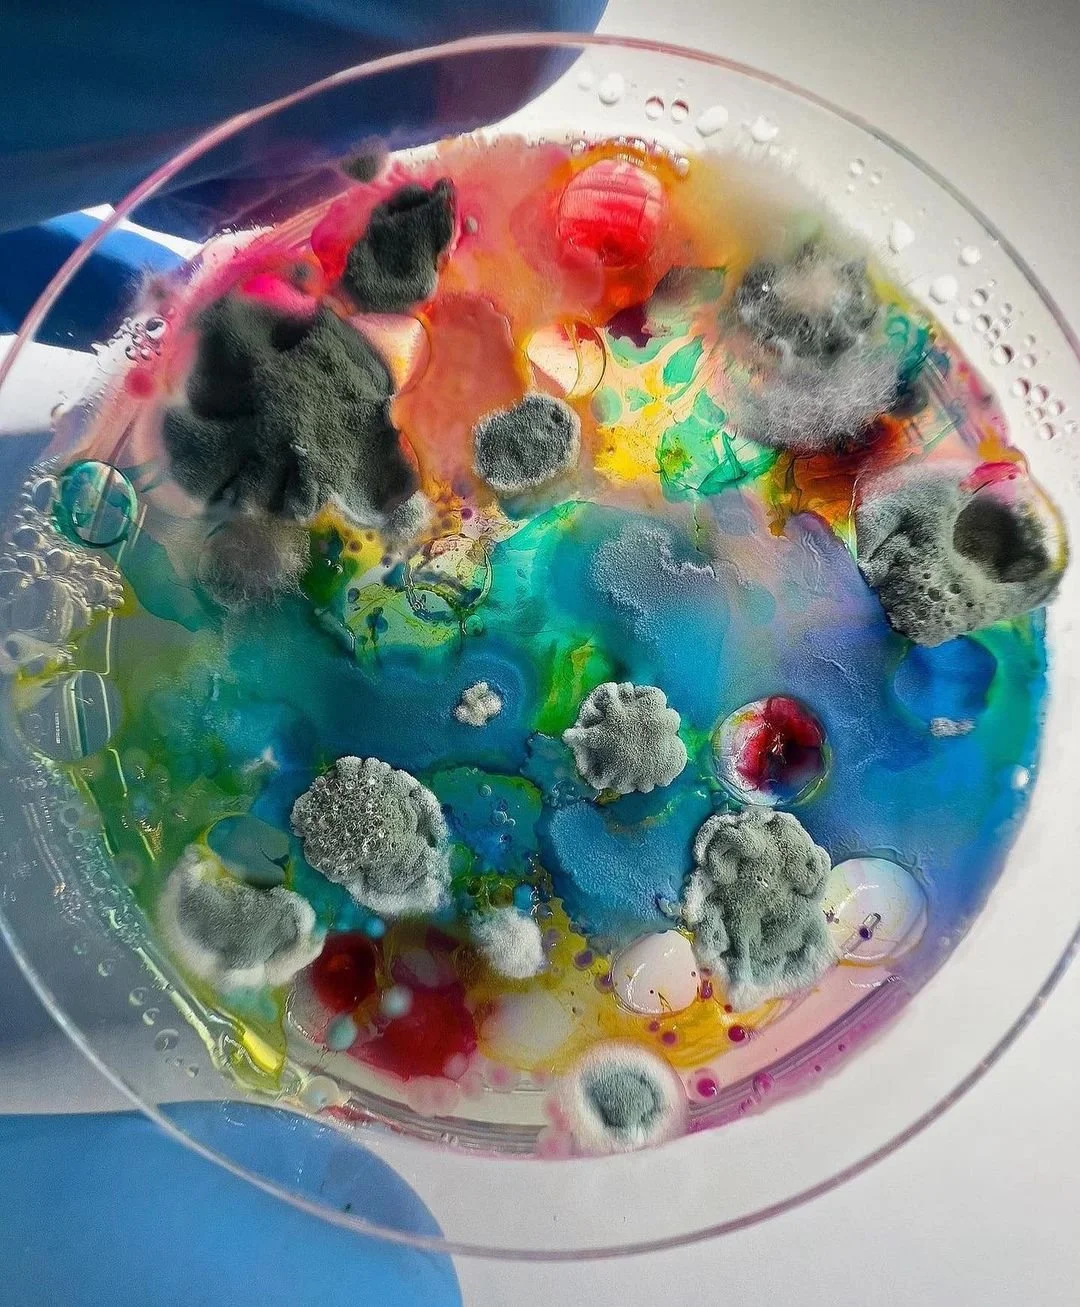

Malama Mushrooms
Malama Mushrooms is a family-owned, superfood mushroom company dedicated to sharing the health and wellness benefits of mushrooms with the world. Through our marketing services, including content creation, social media management, and events and partnerships, Malama Mushrooms can now be found on shelves across the country. Their fung-tional family continues to grow with new members joining their community of 77,000+ on Instagram and 25,000+ on TikTok.
Services:
✘ Brand Partnerships
✘ Content Creation
✘ Events
✘ Influencer Marketing
✘ Social Media Management